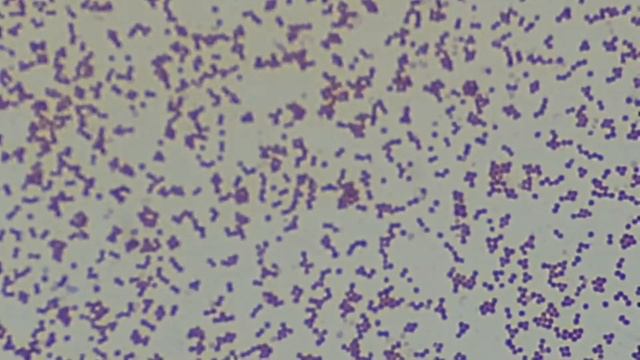

Автор / Канал: Растения для вашего сердца Страница 4
Staphylococcus aureus in Gram stained smear of culture under the Microscope at various magnificatio

1 MİLYON PLAKETİNİ YEDİM!

MY MAKEUP COLLECTION (PALETTES) !!!

Ночью в Санкт Петербурге.1 ролик: На набережной - поём песни, гуляем

Фізика 10 клас. Напруженість 3. Складніші задачі на принцип суперпозиції

ZDSimulator #48-1 Киев-Днепропетровск ч1/3

Я ехала домой

Club mahindra hotel goa !! studio room !! best hotel !! beautiful place !!nearest beach varca !!

HOW TO BONSAI BOUGAINVILLEA ( The Easiest Way)

Вся моя пряжа. Июль 2020

Biscochito Kitchen - Part 1

Plant Q&A 💚 also i repot some philodendron strawberry shakes but I got so distracted so not really

Силиконовая форма для мыла «Скабиоза звездчатая»

Ayled T. Zuluaga & Javier Palma - Palma's Realty

Stay Cation Hotel Mewah SVARGA RESORT LOMBOK

бой за 3 место, Годзилла против Конга

ДОКТОР ГЕББЕЛЬС О ЗАЯВЛЕНИИ МУССОЛИНИ, ЧТО "ЧЕСТЬ ИТАЛЬЯН. ОРУЖИЯ БЫЛА НЕМЫСЛИМЫМ ОБРАЗОМ ОПОЗОРЕНА

Рисование для детей. Рисуем слонёнка.

Morning walk through beautiful Amstelpark 4K | Amsterdam, the Netherlands | City Park Walking Tour

Vivetochka искусственное банановое дерево

Какой же он, сад мечты?

Ура,меня никто не любит meme/Gacha life/lюtik

Deeply Relaxing & Uplifting, Meditation for Self-Healing, Midsummer Meditation with Sounds of Natur

Мир на планете, слова и музыка Л.В.Чернышова
За каждым успешным каналом стоит личность, идея и сотни часов кропотливого труда. Если вы здесь, значит, автор «Растения для вашего сердца» уже сумел зацепить ваше внимание своим уникальным стилем или подачей. А мы на RUVIDEO позаботились о том, чтобы вы могли изучить весь архив его работ в максимально комфортных условиях — без лишней суеты и преград.
Почему за работами канала «Растения для вашего сердца» так интересно наблюдать? Всё просто: это честный контент, который находит отклик в сердцах зрителей. На нашем ресурсе вы можете смотреть онлайн все видео любимого автора бесплатно и в хорошем качестве. Нам важно, чтобы вы видели каждую деталь и слышали каждый нюанс, поэтому мы используем только стабильные плееры из открытых источников Rutube.
Следите за новинками канала, пересматривайте старые шедевры и открывайте для себя новые грани творчества «Растения для вашего сердца». Мы постоянно обновляем ленту, чтобы у вас под рукой всегда были самые свежие выпуски. Никаких сложных регистраций — только вы и творчество, которое вдохновляет. Приятного вам путешествия по миру авторского контента на RUVIDEO!
Видео взято из открытых источников Rutube. Если вы правообладатель, обратитесь к первоисточнику.